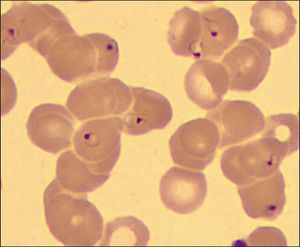

During a flight from Houston to New York, a 46-year-old man had fever, chills, rigors, and body aches. After he landed, he sought treatment at a local hospital. The patient was on his way back to Liberia, where he works. He had been at home in Houston for several weeks. In the emergency department, he complained only of subjective fever.